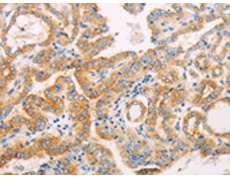
一抗

|
Background: |
The Hedgehog signaling pathway plays an important role in early human development. The pathway is a signaling cascade that plays a role in pattern formation and cellular proliferation during development. This gene encodes a negative regulator of the hedgehog signaling pathway. Defects in this gene are a cause of medulloblastoma. Alternative splicing results in multiple transcript variants. |
|
Applications: |
ELISA, WB, IHC |
|
Name of antibody: |
SUFU |
|
Immunogen: |
Fusion protein of human SUFU |
|
Full name: |
SUFU negative regulator of hedgehog signaling |
|
Synonyms: |
SUFUH; JBTS32; SUFUXL; PRO1280 |
|
SwissProt: |
Q9UMX1 |
|
ELISA Recommended dilution: |
1000-2000 |
|
IHC positive control: |
Human thyroid cancer and Human colon cancer |
|
IHC Recommend dilution: |
15-50 |
|
WB Predicted band size: |
54 kDa |
|
WB Positive control: |
Jurkat cells |
|
WB Recommended dilution: |
200-1000 |


 購物車
購物車 幫助
幫助
 021-54845833/15800441009
021-54845833/15800441009